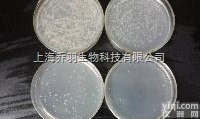
<em>DMSO细胞培养基（低毒性细胞冻存成活率95%）</em>

大鼠胎盘生长因子(PLGF)ELISA KitRat placenta growth factor,PLGF ELISA kit 96T
大鼠P选择素(P-Selectin/CD62P)ELISA kit Rat P-Selectin ELISA kit 96T
大鼠正常T细胞表达和分泌因子(RANTES/CCL5)ELISA kit Rat regulated on activation in normal T-cell expressed and secreted,RANTES ELISA kit 96T
大鼠可溶性白细胞分化抗原30配体(sCD30L)ELISA KitRat Soluble Cluster of differentiation 30 ligand,sCD30L ELISA Kit 96T
大鼠可溶性白细胞分化抗原40配体(sCD40L)ELISA Kit Rat Soluble Cluster of differentiation 40 ligand,sCD40L ELISA Kit 96T
大鼠干细胞因子受体(SCFR)ELISA KitRat Stem Cell Factor Receptor,SCFR ELISA kit 96T
大鼠基质细胞衍生因子1β(SDF-1β/CXCL12)ELISA Kit Rat Stromal cell derived factor 1β,SDF-1β ELISA Kit96T
大鼠血管生成素受体Tie1(ANG-R-Tie1)ELISA KitRat angiopoietin receptor Tie1,ANG-R-Tie1 ELISA kit 96T
大鼠血管生成素受体Tie2(ANG-R-Tie2)ELISA KitRat angiopoietin receptor Tie2,ANG-R-Tie2 ELISA kit 96T
大鼠基质金属蛋白酶YZ因子2(TIMP-2)ELISA KitRat tissue inhibitors of metalloproteinase 2,TIMP-2 ELISA Kit96T
大鼠基质金属蛋白酶YZ因子3(TIMP-3)ELISA KitRat tissue inhibitors of metalloproteinase 3,TIMP-3 ELISA Kit96T
大鼠基质金属蛋白酶YZ因子4(TIMP-4)ELISA KitRat tissue inhibitors of metalloproteinase 4,TIMP-4 ELISA Kit96T
大鼠肿瘤坏死因子可溶性受体Ⅰ(TNFsR-Ⅰ)ELISA KitRat Tumor necrosis factor soluble receptor Ⅰ,TNFsR-Ⅰ ELISA KIT 96T
大鼠肿瘤坏死因子可溶性受体Ⅱ(TNFsR-Ⅱ)ELISA KitRat Tumor necrosis factor soluble receptor Ⅱ,TNFsR-Ⅱ ELISA KIT 96T
大鼠肿瘤坏死因子β(TNF-β)ELISA KitRat Tumor necrosis factor β,TNF-β ELISA KIT 96T
大鼠血小板生成素(TPO)ELISA Kit
Rat Thrombopoietin,TPO ELISA kit
96T